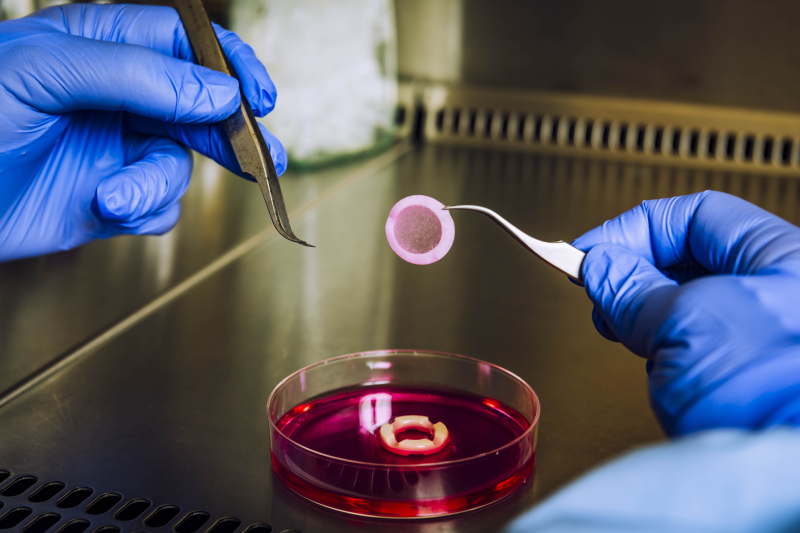

INCREASE : des modèles 3D de peau pour tester les dispositifs médicaux
Le Groupe Icare et le laboratoire I2CT du CNRS se sont rapprochés afin de créer le laboratoire commun INCREASE. Son objectif : mettre au point des modèles 3D de peau sur puce microfluidique, pour limiter le recours aux expérimentations sur animaux lors de l’évaluation de la conformité des dispositifs médicaux et des produits chimiques.
Avant d’être mis sur le marché, tout dispositif médical doit passer un grand nombre de tests biologiques et toxicologiques, afin de vérifier sa conformité aux normes en vigueur et ainsi d’assurer la sécurité du patient et de l'utilisateur. Ces évaluations doivent respecter des normes à différentes échelles (internationale et nationale), qui définissent les protocoles à suivre. Outre la toxicité cellulaire et l’irritation, les tests de sensibilisation cutanée (allergie), induite par des substances chimiques extractibles des dispositifs médicaux, sont un élément clé de la norme ISO 10993-10 (2021).
Cela implique, à l’heure actuelle, de réaliser des tests sur animaux (souris, cobayes). « Mais la donne est en train de changer », annonce Edith Filaire, Professeur des Universités et Directrice Recherche Innovation du Groupe Icare (Saint-Beauzire, 63). « La récente norme ISO 10993-23:2021 encourage le recours à des essais in vitro, plutôt qu’aux tests in vivo, pour l’évaluation du potentiel irritant des dispositifs médicaux. » Une avancée significative, même s’il ne s’agit pas d’une obligation, contrairement aux lois européennes qui, depuis 2013, interdisent les expérimentations animales pour tous les produits cosmétiques.
Mais comment évaluer la biocompatibilité d’un dispositif médical, sans recourir à des tests in vivo ? Si des modèles 3D de peau ont été élaborés ces dernières années afin de répondre à cet objectif, ceux-ci présentent des limites. « En général, les modèles actuellement acceptés pour des tests réglementaires reproduisent seulement l’épiderme », relève Vincent Flacher, chargé de recherche CNRS au laboratoire d’Immunologie, Immunopathologie et Chimie Thérapeutique (I2CT), à Strasbourg. « Cette couche est bien sûr importante, mais elle ne reflète pas à elle seule la variété de fonctions de la peau, qui comprend également des cellules immunitaires, sensorielles, ou encore vasculaires. »
La complexité dans la peau
Il s’agit, au contraire, de l’objectif du laboratoire commun INCREASE (ImmuNocompétence et vasCulaRisation de pEAu Sur pucE), inauguré le vendredi 10 novembre 2023 et codirigé par Edith Filaire et Vincent Flacher. La collaboration, associant le Groupe Icare et le laboratoire I2CT, vise en effet à créer des modèles 3D de peau complexes, comprenant des cellules immunitaires et un système vasculaire, afin de se rapprocher de l’organe humain et de proposer un nouveau support d’évaluation pour les dispositifs médicaux.
Néanmoins, avant d’être utilisés lors des tests de conformité, les modèles devront faire l’objet d’une validation par les organismes de standardisation. « Le Groupe Icare siège au sein de comités de normalisation sur l’évaluation biologique des dispositifs médicaux, notamment à l’AFNOR (Association française de normalisation) », souligne Edith Filaire. « Notre but est de présenter les résultats de notre collaboration à ces comités et d’obtenir la validation des modèles que l’équipe d’INCREASE aura mis au point. »
Des modèles 3D de peau reproductibles et intégrés sur des puces microfluidiques
Afin de les satisfaire, les chercheurs devront relever plusieurs défis scientifiques, à commencer par celui de la reproductibilité. « D’ordinaire, pour élaborer de tels modèles, nous travaillons à partir de cellules primaires, c’est-à-dire extraites de la peau ou du sang d’un individu », explique Vincent Flacher. « Cela rend difficile la reproduction d’un modèle donné, puisque les cellules primaires peuvent se comporter différemment selon les individus d’origine. Notre premier objectif est donc de disposer de lignées cellulaires : des cellules homogènes et bien caractérisées, qui constitueront les "pièces de puzzle" du modèle 3D. » Cette approche standardisée permettra de diminuer la variabilité des modèles créés, et ainsi de faciliter leur industrialisation.
Ensuite, l’équipe d’INCREASE entend développer un système de « skin-on-chip » (« peau sur puce »), en intégrant son modèle dans un environnement de culture sur puce microfluidique. « Nous allons connecter notre modèle à un système de "tuyauterie" à l’échelle micrométrique », schématise le codirecteur du laboratoire commun. « Le but est alors d’apporter des nutriments au modèle pendant sa culture in vitro, de façon contrôlée et automatisée, mais aussi d’effectuer des prélèvements réguliers de ce qui est produit par les cellules du modèle lors de son exposition à une molécule ou à un dispositif médical. »
De la réflexion scientifique à l’utilisation finale
Comment s’assurer que le modèle ainsi élaboré reproduit fidèlement le comportement de la peau humaine ? « Au sein du Groupe Icare, nous testons tous les jours des dispositifs médicaux, via des essais in vivo et in vitro », indique Edith Filaire. « Nous disposons donc d’un grand nombre de références d’évaluation, que nous allons comparer aux résultats fournis par les modèles 3D élaborés dans le cadre du laboratoire commun. C’est ce qui rend cette collaboration si riche : elle allie recherche scientifique, développement d’une solution et utilisation par de véritables utilisateurs finals. »
INCREASE représente ainsi un nouveau témoignage de la complémentarité entre les mondes académique et industriel, qui se traduira également par le lancement d’une thèse CIFRE, codirigée par Vincent Flacher et Edith Filaire. Une manifestation supplémentaire de l’ambition commune du Groupe Icare et du laboratoire I2CT de permettre, à terme, aux évaluations toxicologiques de dispositifs médicaux de faire peau neuve, en réduisant les expérimentations animales.